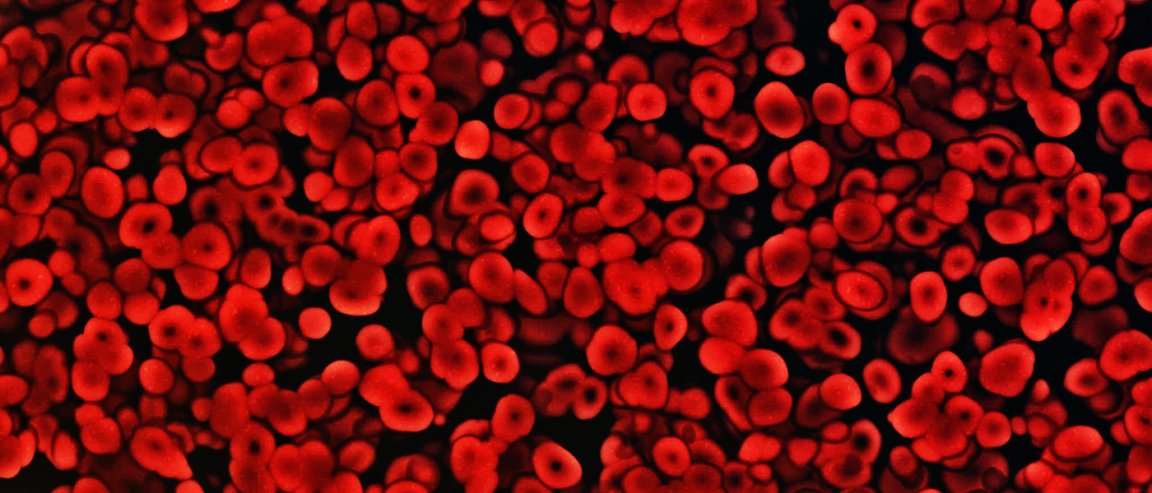

Intellectual Ventures Laboratory has built a new microscope equipped with artificial intelligence to accurately detect malaria from blood samples. The results of their study were published in IEEE Explore.
IVL is the research facility of Intellectual Ventures located in Seattle, which is owned by Charles Delahunt. The development of this new microscope was funded by Bill and Melinda Gates as part of the Global Good Fund.
A more accurate microscope

The new microscope is called Autoscope. It is 15 inches tall and 7 inches wide. The microscope itself is enclosed in a white box, and it is connected to a laptop that uses deep learning to analyze microscopic images.
The team “trained” the deep learning software to identify images from 120 slides gathered from patients who are both infected and not infected by malaria. It uses visual features like shape, color, and texture to classify if a slide contains a sample that has the malaria parasite.
The Autoscope was tested at the Shoklo Malaria Research Unit during the malaria season from December 2014 until January 2015. This research facility was located on the Thailand-Myanmar border, and a total of 170 samples were tested by the Autoscope.
“It could have broad applicability, not only in research and surveillance of antimalarial drug resistance but also in clinical practice,” says Mehul Dhorda, head of the Asia Regional Center at the WorldWide Antimalarial Resistance Network. Dhorda works with Intellectual Ventures on some of the current Autoscope trials but was not an author of the research.
Malaria Detection and Treatment
Malaria is a seriously life-threatening disease that comes from Plasmodium parasites. The parasites are injected into the human body through female mosquitoes called “malaria vectors”. There are 5 species of parasites that cause malaria, and two of them are fatal.
An estimated 3.2 billion people around the globe are at risk of being infected by malaria. A majority of malaria cases are found in Sub-Saharan Africa, but recently it has spread to Latin America and Asia. However, this disease is preventable and most importantly, it is curable.
The best way to prevent this disease is to make sure that protection against mosquito bites are solid. Mosquito nets, sprays, and insecticides rank high among the prevention list. Also of note, malaria is best treated when diagnosed early. The current treatment is artemisinin-based combination therapy (ACT).
Right now, there are two ways to diagnose malaria: microscopy and rapid diagnostic tests. Rapid diagnostic tests are portable cards that display bands in the presence of malaria, much like an at-home pregnancy test. It is inexpensive, but it is also prohibitive, having a number of limitations. Microscopy is more expensive, but slides can be re-used for other patients.
“If you have a severely ill child with severe malaria, then it’s important that you control the parasite density. Every six hours you want to see, is it coming down? Is my treatment having an effect?” says Albert Kilian, a public health and malaria expert at Tropical Health consultancy. “And in these cases, [rapid diagnostic tests] don’t serve, so you need to count [the parasites].”
To that end, microscopy is the best option to look out for malaria, but in most cases the availability of microscopes in infected areas are scarce. There are also not enough people trained to look into microscopes to provide an accurate diagnosis.
Autoscope solves this dilemma because anyone can use it and utilize it. “We’re not as good as the very best humans, but we’re certainly better than almost all microscopists in the field,” according to the World Health Organization’s standards, says Delahunt.
Despite its awesome features, there are still some drawbacks. The Autoscope runs on electricity, so it is useless in remote areas where electricity runs short. Another issue is cost. IVL is looking for a commercial partner so that it can lower down the cost of the Autoscope from $4,000 to $1,500.
The Autoscope will be making rounds in Peru and Southeast Asia this year for more tests and to give support for drug-resistant malaria cases.